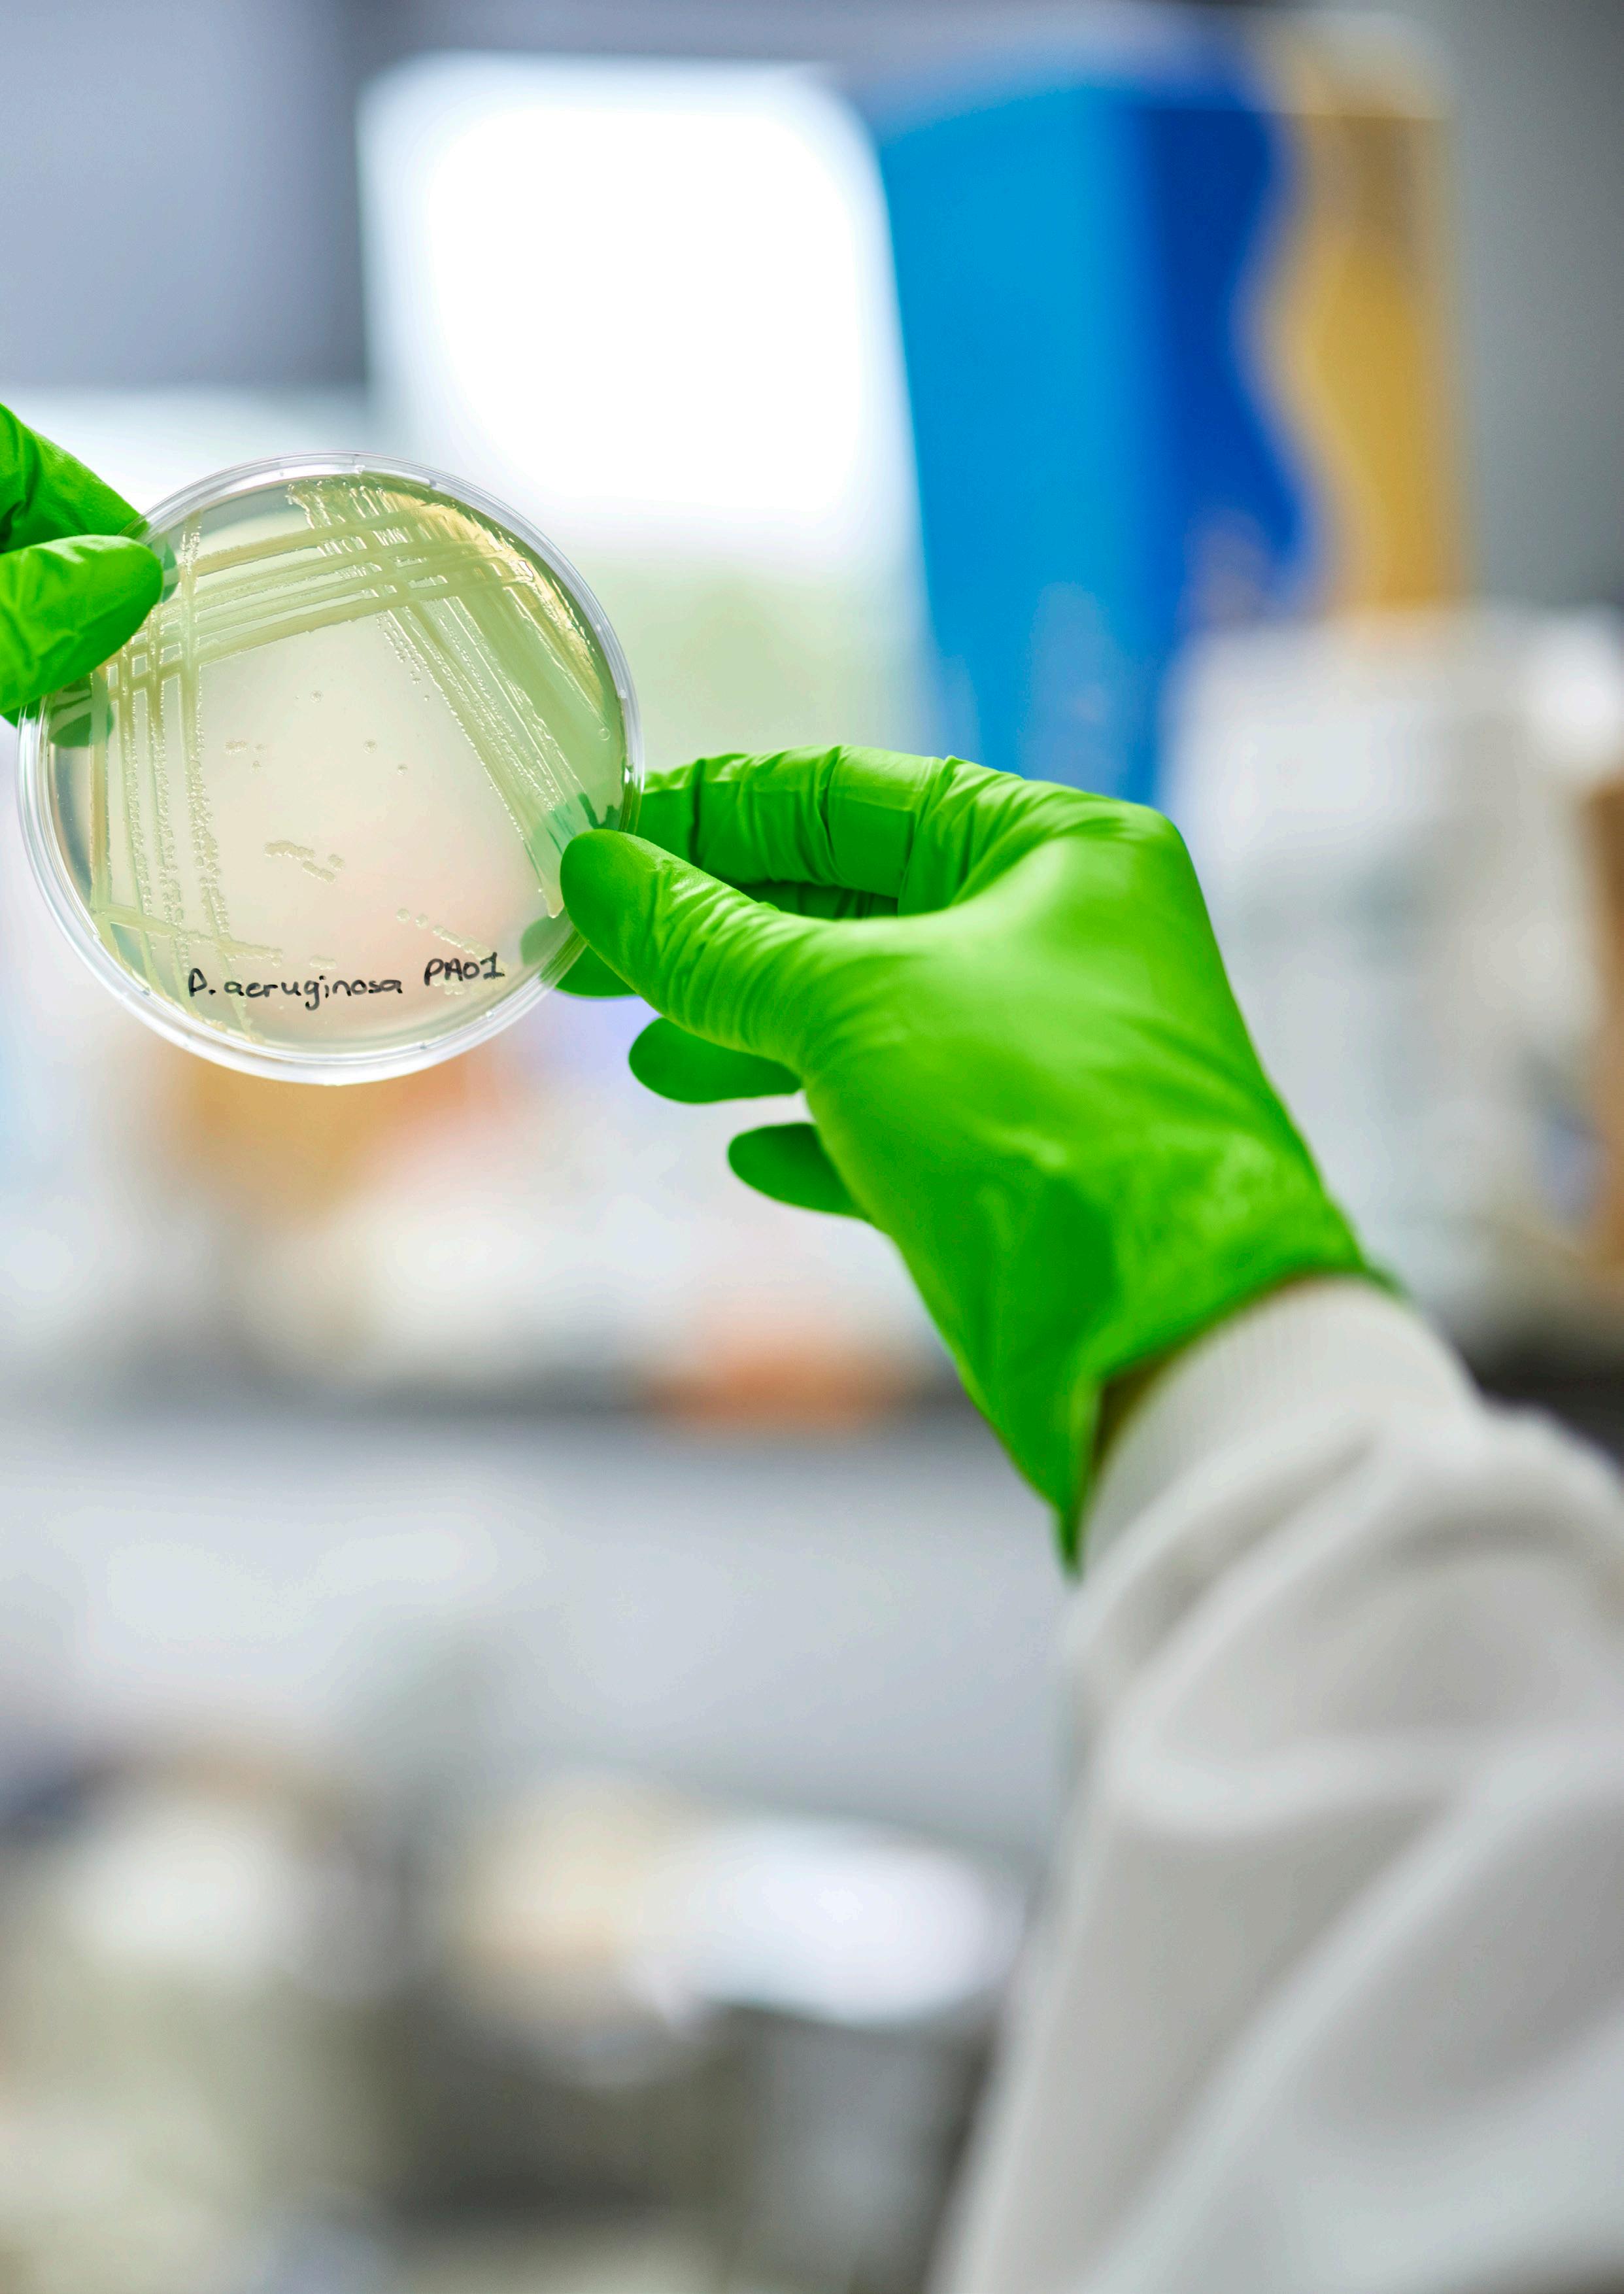

Using Therapeutic Target Product Profiles to Improve the Lives of People with Cystic Fibrosis








Cystic fibrosis (CF) is an inherited, lifelimiting disease affecting over 11,000 people in the UK. It causes a build-up of thick sticky mucus in the lungs, digestive system and other organs, causing a wide range of challenging symptoms affecting the entire body. People with CF currently manage their health by taking different medications multiple times a day and on a long-term basis, together with physiotherapy
and making dietary changes. Antimicrobials are vital to managing acute pulmonary flare-ups, known as exacerbations, and to help suppress or manage long-term chronic lung infections. Treatment failure due to antimicrobial resistance (AMR) is a frequent and significant challenge. Given this and the rise of AMR, new tolerable yet effective treatments are urgently needed.

The CF AMR Syndicate is a crosssector initiative established in 2019 and jointly managed by Medicines Discovery Catapult, Cystic Fibrosis Trust and LifeArc. It brings together leading experts in CF and AMR from industry, academia and the clinic with people living with CF. Through this partnership, the CF AMR Syndicate has generated a set of Target Product Profiles (TPPs) for CF therapies. People with CF, their loved ones and CF experts were central to the preparation of the TPP document.
The patient-focused therapeutic TPPs have been developed around the needs of people with CF and are intended to guide drug discovery efforts, focusing them where they are needed the most. The TPPs describe characteristics that new antimicrobials would need to have to meet the needs of people with CF.
Three different TPPs are outlined: one describes the overarching requirements any new antimicrobial would need to meet in order to address the needs of people with CF. A further two are aimed at the treatment of acute and chronic infections of Pseudomonas aeruginosa and Mycobacterium abscessus. The TPPs can also be used to guide the development of antimicrobials for other problematic CF-relevant pathogens (e.g. other Gram-negative pathogens including Burkholderia spp., non-tuberculous mycobacteria and fungi).
The TPPs, published in early 2022, have since been used by the CF AMR Syndicate as
the focus for a £3m antimicrobial discovery funding call launched in 2023. As a result of this call, six projects with the potential to fulfil the unmet needs outlined in the TPPs have been selected for collaborative funding. Further details relating to these projects will be released shortly.
The progress arising from these therapeutic CF TPPs and the associated funding call has demonstrated the crucial role partnerships play. Not only have these TPPs generated useful knowledge for the scientific community, but they have also given a voice to people affected by CF in order to address their unmet needs.
Thank you to everyone within the CF community, especially people with lived experience of CF, who have been involved in TPP discussions and their establishment.
We would like to reach out to as many people as possible, both within the UK and globally, to make advances for people with CF. You can help us by sharing these TPPs with your connections and those involved in this space.
Click here to request a copy of the TPPs
“Reflecting on the journey since July 2020, when the CF community shared its insights, it is truly inspiring and, for me, sets a really good example of true patient involvement that is of value. Witnessing how our input has been incorporated throughout the process makes us as a community feel heard and valued and that we have contributed to making a difference. For me, this demonstrates the power of patient/community involvement from the outset, benefiting everyone involved in the journey and, in the long term, the patients using those new medicines/products. I’d like the CF AMR Syndicate and the product developers to continue engaging the CF community along their journey and also thank them for their valuable contribution.”
Angelo (adult with CF)
“The update on the progress with the TPPs is fantastic news, and I feel privileged and honoured to play a small part in this. The generosity of these organisations is truly impressive, especially at times when there are many financial strains.”
Tim (grandparent of a child with CF)
“Being invited to contribute to the development of the TPPs has provided much-needed reassurance that the demand for new or improved antibiotics for people with CF is still recognised as a critical requirement. There has been so much positive press since the introduction of Kaftrio that the perception may be that people with CF are just OK now. However, the new and revealed uncertainties in our health, particularly around lung health and infection diagnosis and management, alongside an unknown future of increasing age, have amplified aspects of mental health. Having sight of the expertise and enthusiasm of collaborating via the CF AMR Syndicate provides that reassurance, especially knowing my experiences and lived expertise have been woven through the programme.”
Simon (adult with CF)
Managed by

